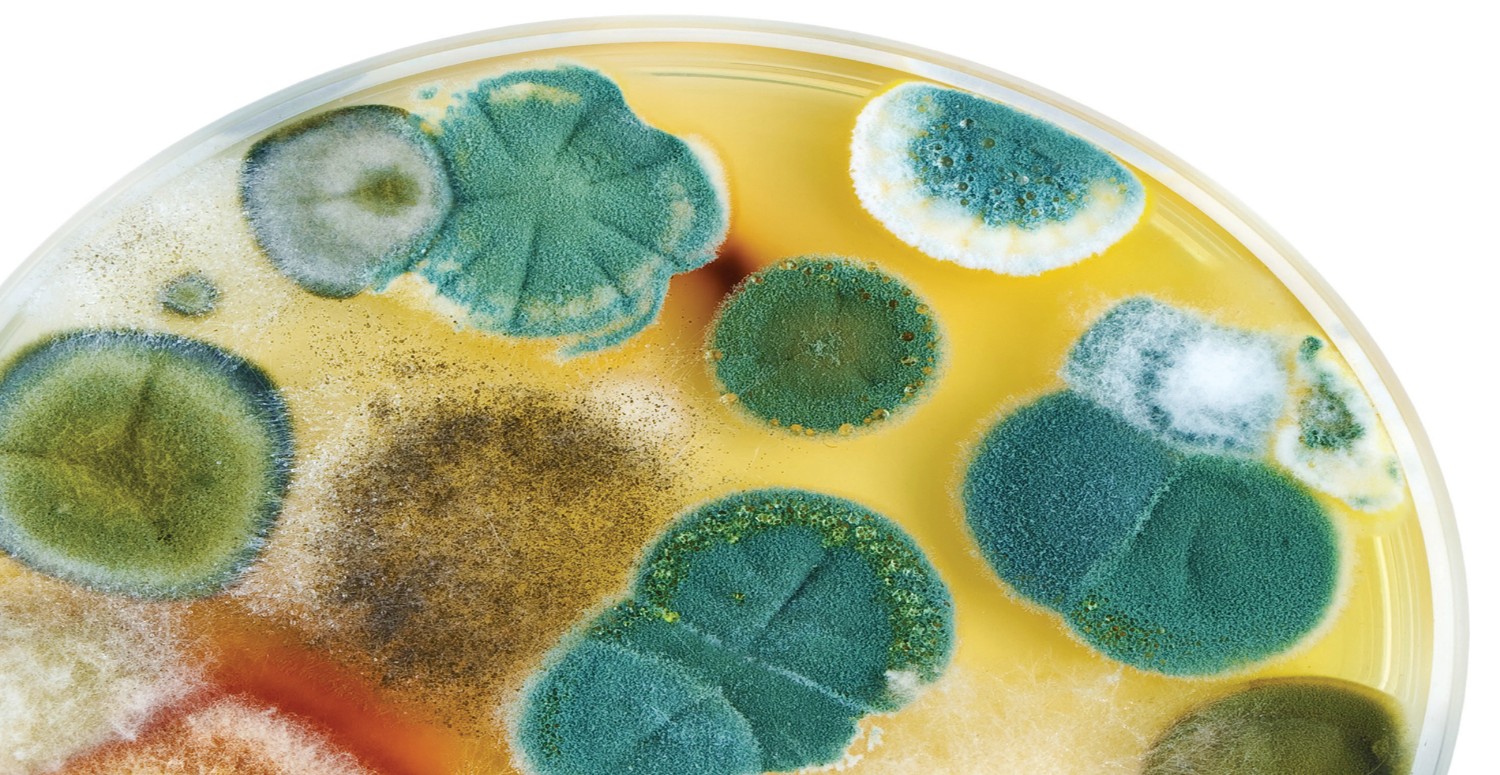
KÜF MANTARI OLUŞUMU

Küf hastalığı, küf mantarlarının neden olduğu ciddi bir sağlık sorunudur. Küf hastalığı, özellikle nemli ve rutubetli ortamlarda yaşayan veya çalışan kişilerde görülür. Küf hastalığı, erken teşhis ve tedavi edilmediği takdirde, ölümcül sonuçlara neden olabilir. O halde küf mantarlarından nasıl korunabiliriz? Belirtileri ve tedavi yöntemleri hakkında her şey haber içeriğimizde...
KÜF HASTALIĞI NEDİR?
Küf hastalığı, küf mantarlarının insan vücuduna girmesiyle oluşur. Küf mantarları, havada, toprakta, bitkilerde, yiyeceklerde ve su kaynaklarında bulunabilir. Küf mantarları, nemli ve sıcak ortamlarda ürer ve sporlar halinde havaya yayılır. Bu sporlar, solunum yoluyla, yaralarla veya yiyeceklerle vücuda girebilir.

Vücutta, bağışıklık sisteminin zayıf olduğu veya yeterli savunma mekanizmasının olmadığı bölgelerde enfeksiyon oluşturabilir.
KÜF MANTARININ BELİRTİLERİ NELERDİR?
Küf hastalığının belirtileri, enfekte olan organa ve mantar türüne göre değişiklik gösterebilir. Genel olarak, küf hastalığının belirtileri şunlardır:
Solunum Yolu Enfeksiyonu
Öksürük, balgam, nefes darlığı, göğüs ağrısı, hırıltı, ateş, burun akıntısı, boğaz ağrısı, sinüs enfeksiyonu, astım, alerji, zatürre gibi belirtiler görülebilir.
Cilt Enfeksiyonu
Kaşıntı, kızarıklık, şişlik, döküntü, yara, kabuklanma, ülser, egzama, mantar enfeksiyonu gibi belirtiler görülebilir.
Göz Enfeksiyonu
Kızarıklık, şişlik, akıntı, kaşıntı, yanma, ışığa hassasiyet, görme bozukluğu, konjonktivit, keratit, endoftalmit gibi belirtiler görülebilir.

Sinüs Enfeksiyonu
Baş ağrısı, yüz ağrısı, burun tıkanıklığı, burun akıntısı, koku alma bozukluğu, ateş, halsizlik, sinüzit, polip, kronik rinit gibi belirtiler görülebilir.
Beyin Enfeksiyonu
Baş ağrısı, ateş, kusma, bulantı, nöbet, bilinç bozukluğu, konuşma bozukluğu, felç, menenjit, ensefalit, beyin apsesi gibi belirtiler görülebilir.
Bağırsak Enfeksiyonu
Karın ağrısı, ishal, kanlı dışkı, kilo kaybı, iştahsızlık, gaz, şişkinlik, mide bulantısı, kusma, kolit, ülseratif kolit, Crohn hastalığı gibi belirtiler görülebilir.

KÜF HASTALIĞININ TEDAVİSİ NASILDIR?
Küf hastalığının tedavisi, enfekte olan organa, mantar türüne ve hastalığın şiddetine göre değişiklik gösterebilir. Genel olarak, küf hastalığının tedavisinde şu yöntemler kullanılır:
Antifungal İlaçlar
Mantar enfeksiyonunu yok etmek veya durdurmak için ağızdan, damardan veya lokal olarak uygulanan ilaçlardır. Antifungal ilaçların etkinliği, mantar türüne, enfeksiyonun yaygınlığına ve hastanın bağışıklık durumuna göre değişebilir. Antifungal ilaçlar, yan etkilere neden olabilir. Bu nedenle, doktorun önerisi ve gözetimi altında kullanılmalıdır.
Cerrahi Müdahale
Enfekte olan organ veya dokunun tamamen veya kısmen alınması işlemidir. Cerrahi müdahale, enfeksiyonun yayılmasını önlemek veya hayati organların işlevini korumak için gerekebilir.
Cerrahi müdahale, komplikasyonlara neden olabilir. Bu nedenle, doktorun kararı ve izni ile yapılmalıdır.
Destekleyici Tedavi
Enfeksiyonun neden olduğu belirtileri hafifletmek veya gidermek için uygulanan tedavidir. Destekleyici tedavi, ağrı kesiciler, ateş düşürücüler, antihistaminikler, kortikosteroidler, sıvı tedavisi, oksijen tedavisi, kan transfüzyonu gibi yöntemleri içerebilir. Destekleyici tedavi, enfeksiyonu tedavi etmez, sadece hastanın rahatlamasını sağlar.
KÜF HASTALIĞINA KARŞI ALINACAK ÖNLEMLER NELERDİR?
Küf hastalığı, ciddi bir sağlık sorunudur ve erken teşhis ve tedavi edilmediği takdirde, ölümcül sonuçlara neden olabilir. Küf hastalığından korunmak için, şu önlemler alınabilir:
* Küf oluşumuna elverişli ortamlardan uzak durun. Nemli, rutubetli, sıcak, havasız, karanlık, tozlu ortamlarda yaşamayın veya çalışmayın. Bu ortamlarda küf mantarları kolayca ürer ve sporlar halinde havaya yayılır. Bu sporlar, solunum yoluyla, yaralarla veya yiyeceklerle vücuda girebilir.

* Küf oluşumunu önleyin. Ev, iş yeri, okul, depo, bodrum gibi yerlerde küf oluşumunu önlemek için, havalandırma, ısıtma, soğutma, nem alma, temizlik gibi yöntemleri uygulayın. Küf oluşmuşsa, uygun şekilde temizleyin veya temizletin. Küf temizliği yaparken, koruyucu maske, eldiven, gözlük gibi ekipmanları kullanın.
* Küf bulaşmış yiyecekleri tüketmeyin. Küf bulaşmış yiyecekler, mantar sporlarını içerir ve vücuda girdiğinde enfeksiyona neden olabilir. Küf bulaşmış yiyecekleri tüketmeyin, atın veya hayvanlara vermeyin. Küf bulaşmış yiyecekleri saklamayın, buzdolabında bile olsa. Küf bulaşmış yiyeceklerle temas ettikten sonra ellerinizi yıkayın.
* Bağışıklık sisteminizi güçlendirin. Bağışıklık sistemi, vücudu mantar enfeksiyonlarına karşı koruyan bir savunma mekanizmasıdır. Bağışıklık sisteminizi güçlendirmek için, sağlıklı ve dengeli beslenin, yeterli uyuyun, stresten uzak durun, egzersiz yapın, sigara ve alkol kullanmayın, kronik hastalıklarınız varsa tedavi olun, aşılarınızı yaptırın.

* Doktora başvurun. Küf hastalığı belirtileri gösteriyorsanız, vakit kaybetmeden doktora başvurun. Doktorunuz, enfeksiyonun türünü, şiddetini ve yaygınlığını belirlemek için gerekli testleri yapacaktır. Doktorunuz, size uygun bir tedavi planı hazırlayacaktır. Doktorunuzun önerilerine uyun, ilaçlarınızı düzenli alın, kontrollerinizi aksatmayın. Küf hastalığı, ciddi bir sağlık sorunudur ve erken teşhis ve tedavi edilmediği takdirde, ölümcül sonuçlara neden olabilir.

